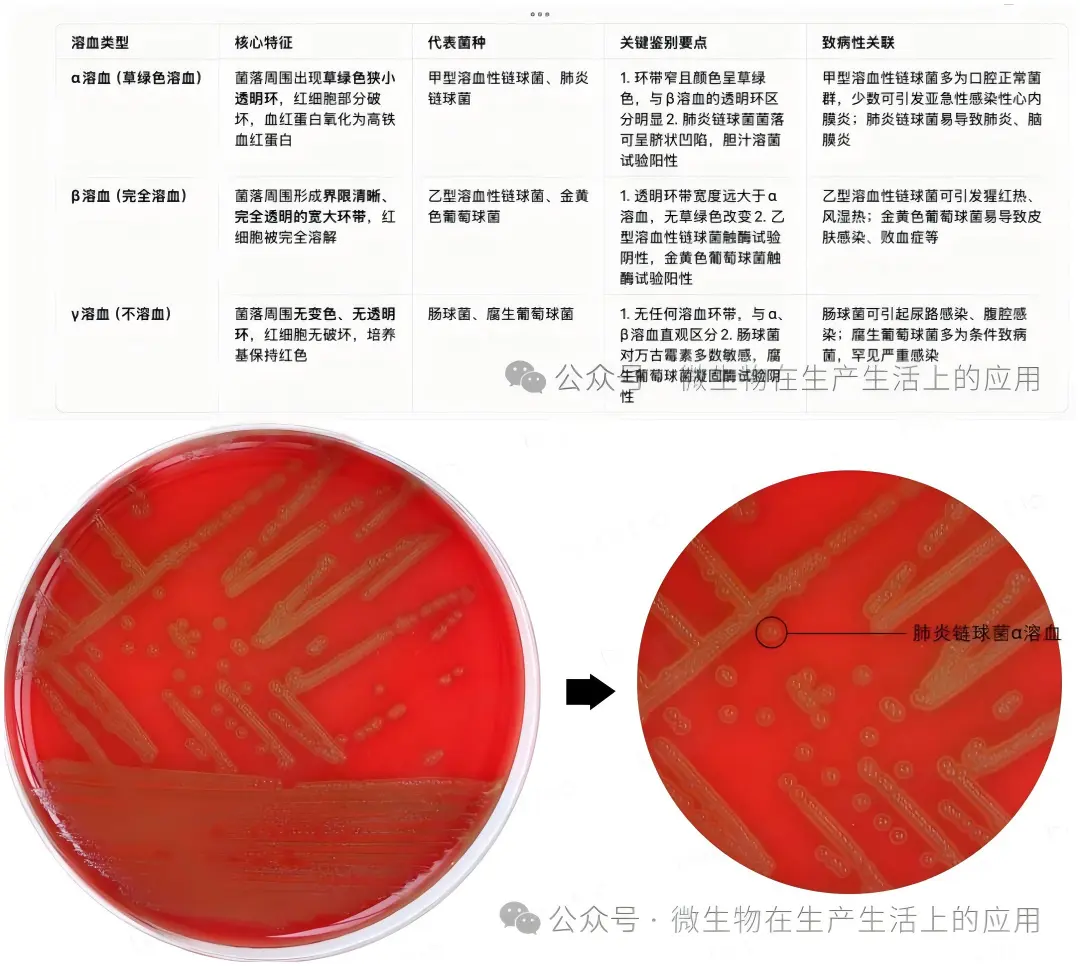
溶血现象

微生物菌种的溶血现象以及影响
发布时间:2026-02-09 浏览次数:79
血平板培养基上的“颜色密码”:微生物溶血现象竟影响这么大!
在微生物实验室的血琼脂平板上,常常能看到神奇的“色彩变化”——有的菌落周围泛着草绿色光环,有的围着透明圆环,还有的毫无动静。这就是微生物的“溶血现象”,看似普通的反应,却藏着鉴别病菌、指导临床的关键信息。
溶血现象是致病菌在血平板生长时,分泌溶血素破坏红细胞的表现,主要分为三类:α溶血(草绿色溶血)、β溶血(完全溶血)和γ溶血(不溶血)。草绿色溶血的菌落周围会出现1-2mm的草绿色半透明环,常见于肺炎链球菌等;β溶血则是宽大的透明环,像“挖空”了培养基,代表菌种有乙型溶血性链球菌;γ溶血则无任何变化,多为肠球菌等条件致病菌。
这一现象在临床上作用重大:医生通过溶血类型能快速锁定致病菌,比如看到β溶血环,需警惕猩红热、败血症等严重感染;草绿色溶血提示可能是肺炎链球菌,助力肺炎、脑膜炎的快速诊断。同时,溶血素的毒性强弱也指导治疗方案,比如β溶血致病菌毒性强,需优先选用强效抗生素,避免延误病情。
在食品和制药领域,溶血现象也是“质检员”。食品中若检出β溶血菌,可能存在安全隐患;制药车间监测到致病性溶血菌,需立即排查污染,保障药品安全。
菌种溶血现象在农业饲料领域的应用影响,主要集中在饲料微生物安全检测和饲用益生菌筛选两大核心方向,直接关系到饲料品质与畜禽养殖安全:
1. 饲料致病性微生物的快速筛查:饲料原料或成品若被具有β溶血特性的致病菌(如乙型溶血性链球菌、金黄色葡萄球菌)污染,其产生的溶血素不仅会破坏畜禽红细胞,还可能引发动物败血症、消化道炎症等疾病,进而影响养殖效益。通过血琼脂平板的溶血试验,可快速识别这类高风险菌株,作为饲料微生物安全达标的重要判定依据,避免污染饲料流入养殖环节。
2. 饲用益生菌的安全性筛选:优质饲用益生菌(如乳酸菌、芽孢杆菌等)需具备无致病性的特点,γ溶血(不溶血) 是筛选的关键指标之一。这类菌株不会产生溶血素,对畜禽机体无损伤,同时能调节肠道菌群平衡;而具有α或β溶血特性的菌株,即便部分是条件致病菌,也会被排除在益生菌候选范围外,保障益生菌饲料的应用安全性。
文章来源于网络,版权归原作者所有,仅供学习参考,如有侵权请联系删除!
